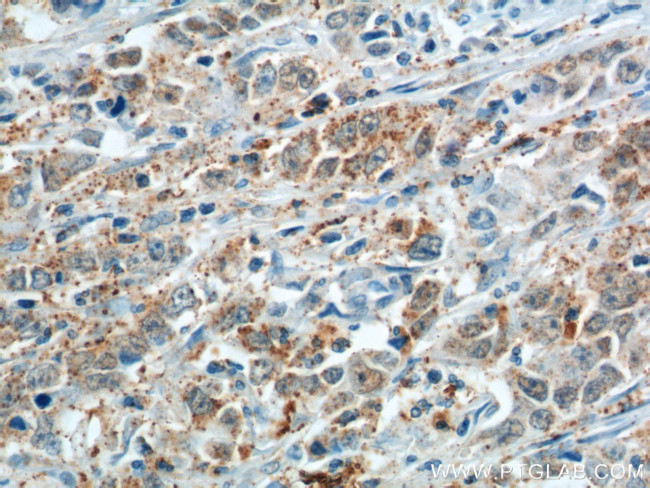
Cathepsin F Antibody in Immunohistochemistry (Paraffin) (IHC (P))

Search
Proteintech
Cathepsin F Polyclonal Antibody
{{$productOrderCtrl.translations['antibody.pdp.commerceCard.promotion.promotions']}}
{{$productOrderCtrl.translations['antibody.pdp.commerceCard.promotion.viewpromo']}}
{{$productOrderCtrl.translations['antibody.pdp.commerceCard.promotion.promocode']}}: {{promo.promoCode}} {{promo.promoTitle}} {{promo.promoDescription}}. {{$productOrderCtrl.translations['antibody.pdp.commerceCard.promotion.learnmore']}}
产品信息
11055-1-AP
种属反应
已发表种属
宿主/亚型
分类
类型
抗原
偶联物
形式
浓度
规格
纯化类型
保存液
内含物
保存条件
运输条件
产品详细信息
Immunogen sequence: EPKSAFTQG SAMISSLSQN HPDNRNETFS SVISLLNEDP LSQDLPVKMA SIFKNFVITY NRTYESKEEA RWRLSVFVNN MVRAQKIQAL DRGTAQYGVT KFSDLTEEEF RTIYLNTLLR KEPGNKMKQA KSVGDLAPPE WDWRSKGAVT KVKDQGMCGS CWAFSVTGNV EGQWFLNQGT LLSLSEQELL DCDKMDKACM GGLPSNAYSA IKNLGGLETE DDYSYQGHMQ SCNFSAEKAK VYINDSVELS QNEQKLAAWL AKRGPISVAI NAFGMQFYRH GISRPLRPLC SPWLIDHAVL LVGYGNRSDV PFWAIKNSWG TDWGEKGYYY LHRGSGACGV NTMASSAVVD (136-484 aa encoded by BC011682)
靶标信息
Cathepsins are papain family cysteine proteinases that represent a major component of the lysosomal proteolytic system. Cathepsins generally contain a signal sequence, followed by a propeptide and then a catalytically active mature region. The very long (251 amino acid residues) proregion of the cathepsin F precursor contains a C-terminal domain similar to the pro-segment of cathepsin L-like enzymes, a 50-residue flexible linker peptide, and an N-terminal domain predicted to adopt a cystatin-like fold. The cathepsin F proregion is unique within the papain family cysteine proteases in that it contains this additional N-terminal segment predicted to share structural similarities with cysteine protease inhibitors of the cystatin superfamily. This cystatin-like domain contains some of the elements known to be important for inhibitory activity. CTSF encodes a predicted protein of 484 amino acids which contains a 19 residue signal peptide. Cathepsin F contains five potential N-glycosylation sites, and it may be targeted to the endosomal/lysosomal compartment via the mannose 6-phosphate receptor pathway. The cathepsin F gene is ubiquitously expressed, and it maps to chromosome 11q13, close to the gene encoding cathepsin W.
仅用于科研。不用于诊断过程。未经明确授权不得转售。
生物信息学
蛋白别名: Cathepsin F; CATSF; CTSF; HGNC:2531; papain-like protease; preproprotein; unnamed protein product
基因别名: AI481912; CATSF; CLN13; CTSF
UniProt ID: (Human) Q9UBX1, (Mouse) Q9R013
Entrez Gene ID: (Human) 8722, (Rat) 361704, (Mouse) 56464